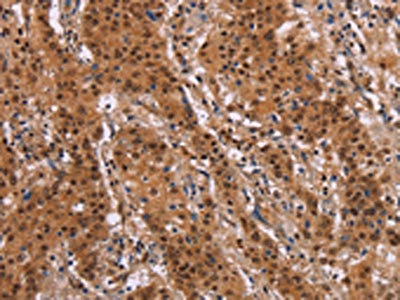

FOSL1 Antibody
-
中文名稱:FOSL1兔多克隆抗體
-
貨號:CSB-PA569524
-
規格:¥1100
-
圖片:
-
The image on the left is immunohistochemistry of paraffin-embedded Human gastric cancer tissue using CSB-PA569524(FOSL1 Antibody) at dilution 1/30, on the right is treated with synthetic peptide. (Original magnification: ×200)
-
Gel: 10%SDS-PAGE,Lysate: 40 μg,Lane 1-2: Hela cells, Jurkat cells,Primary antibody: CSB-PA569524(FOSL1 Antibody) at dilution 1/615 dilution,Secondary antibody: Goat anti rabbit IgG at 1/8000 dilution,Exposure time: 20 seconds
-
-
其他:
產品詳情
-
Uniprot No.:
-
基因名:
-
別名:FOS L1 antibody; FOS like antigen 1 antibody; Fos related antigen 1 antibody; Fos-related antigen 1 antibody; FOSL 1 antibody; FOSL1 antibody; FOSL1 protein antibody; FOSL1_HUMAN antibody; FRA 1 antibody; FRA-1 antibody
-
宿主:Rabbit
-
反應種屬:Human,Rat
-
免疫原:Synthetic peptide of Human FOSL1
-
免疫原種屬:Homo sapiens (Human)
-
標記方式:Non-conjugated
-
抗體亞型:IgG
-
純化方式:Antigen affinity purification
-
濃度:It differs from different batches. Please contact us to confirm it.
-
保存緩沖液:-20°C, pH7.4 PBS, 0.05% NaN3, 40% Glycerol
-
產品提供形式:Liquid
-
應用范圍:ELISA,WB,IHC
-
推薦稀釋比:
Application Recommended Dilution ELISA 1:2000-1:5000 WB 1:500-1:2000 IHC 1:50-1:200 -
Protocols:
-
儲存條件:Upon receipt, store at -20°C or -80°C. Avoid repeated freeze.
-
貨期:Basically, we can dispatch the products out in 1-3 working days after receiving your orders. Delivery time maybe differs from different purchasing way or location, please kindly consult your local distributors for specific delivery time.
-
用途:For Research Use Only. Not for use in diagnostic or therapeutic procedures.
相關產品
靶點詳情
-
基因功能參考文獻:
- High FOS-like antigen 1 (FOSL1) expression with mutant KRAS protein lung and pancreatic cancer patients showed the worst survival outcome. PMID: 28220783
- Our findings indicated that functional SNP rs1892901 in FOSL1 might affect the expression of FOSL1, and ultimately increase the risk of gastric cancer. PMID: 28169308
- Fra1 inhibited the protein levels of Bcl2, cMyc, Survivin, and BclxL. Fra1 overexpression in intestinal mucosal epithelial cells may restrain damage repair after intestinal mucosal injury in inflammatory bowel disease remittent period through weakening the protective effect of intestinal mucosa, thus increasing the risk of recurrence. PMID: 29257201
- High FRA1 expression is associated with Esophageal Squamous Cell Carcinoma. PMID: 27882471
- constitutive activation and non-regulation of Fra-1 by bicalutamide in PC-3 cells suggested that Fra-1, probably a key component, involved in transition of aggressive androgen-independent PC-3 cells with poor prognosis. PMID: 28386843
- the overexpression of Fra1 disrupted inflammatory cytokine secretion by medullary thymic epithelial cells in the myasthenia gravis thymus PMID: 29807388
- Taken together, our results indicated that miR-449 overexpression inhibited osteogenic differentiation of HG-FFA-treated hBMSCs through the Sirt1/Fra-1 signal pathway. PMID: 29305863
- These findings indicate that an aberrant Wnt/beta-catenin signalling leads to the epithelial-mesenchymal transition and drug resistance of glioma via Fra1 induction, which suggests novel therapeutic strategies for the malignant disease. PMID: 28232512
- MUC1 enhancement of ERK activation influences FRA-1 activity to modulate tumor migration, invasion and metastasis in a subset of pancreatic cancer cases PMID: 27220889
- the results indicate that FRA1 promotes cancer growth through AKT, and enhances cancer cell migration through JNK/c-Jun, pinpointing FRA1 as a key integrator of JNK and AKT signaling pathways and a potential therapeutic target for squamous cell carcinoma of the skin and head and neck squamous cell carcinoma. PMID: 27144339
- Study shows that FOSL1 is the main immediate early AP-1 member induced by melanoma oncogenes; found that FOSL1 is involved in melanoma cell migration as well as cell proliferation and anoikis-independent growth. PMID: 28481878
- a Fra-1-miR-134 axis drives a positive feedback loop that amplifies ERK/JNK signaling and reduces chemosensitivity in ovarian cancer cells. PMID: 27685628
- PKCtheta;-induced phosphorylations control the ability of Fra-1 to stimulate gene expression and breast cancer cell migration. PMID: 27816489
- Multivariate analysis identified Fra-1 as an independent prognostic factor. Fra-1 may be involved in the progress of hepatocellular carcinoma and could be a promising molecular candidate in the diagnosis and treatment of hepatocellular carcinoma. PMID: 28653890
- Up-regulation of Fra-1 appeared in retinal ganglion cells following light-induced retina damage. PMID: 27002720
- HGF-induced FRA1 activation is associated with the fibrosis-dependent development of Hepatocellular Carcinoma. PMID: 27134167
- Our results demonstrate that Fra-1 is an important determinant of the metastatic potential of human colon cancer cells, and that the Fra-1 classifier can be used as a prognostic predictor in colon cancer patients. PMID: 26646695
- Results suggest that Fra-1 is upregulated in lung cancer tissues and functions by affecting the P53 signaling pathway. PMID: 26549498
- SIRT1 expression correlated positively with Fra-1 expression, metastasis and overall survival in patients with colorectal cancer PMID: 26975631
- miR-195 can repress the migration and invasion of prostate cancer cells via regulating Fra-1 PMID: 26337460
- Results suggested that Fra-1 expression is low in cervical cancer tissues and promotes apoptosis of cervical cancer cells by p53 signaling pathway. PMID: 25651840
- High Fra-1 expression significantly correlates with shorter overall survival. PMID: 25666264
- Fra-1 induces critical changes in the expression of tgfb1 and Epithelial-to-mesenchymal transition transcription factors through direct binding to the tgfb1, zeb1 and zeb2 genomic regulatory regions. PMID: 25301070
- Fra1 promotes the growth of HaCaT cells in vitro by arresting the cell cycle and inhibiting cell apoptosis. PMID: 25175497
- Intense immunohistochemical staining of Fra-1 was observed at the tumor marginal area adjacent to inflammatory cells and in parallel with IL-6 secretion and STAT3 activation in colorectal cancer tissues. PMID: 25750173
- These results suggest that FOSL1 may be related to IgAN severity. PMID: 24652774
- FRA1 plays an important role in mediating cross talk between oncogenic RAS-ERK and TGFbeta signaling networks during tumor progression. PMID: 24658684
- CD44 dysregulated the activation of the Fra1 gene. The interaction of Fra-1 and CD44 may therefore be important in cervical carcinoma. PMID: 24604526
- we review the current knowledge of av and b3 transcriptional regulation in endothelial cells and discuss the role of FOSL1 in angiogenesis PMID: 24084233
- Data indicate that estrogen induced the expression of c-Jun, Fra-1, c-Fos, cyclin D1 and cyclin E1 while tamoxifen (TMX) decreased the expression. PMID: 23625206
- MicroRNA-34 suppresses breast cancer invasion and metastasis by directly targeting Fra-1. PMID: 23001043
- Fra-1 and c-Fos have roles in supporting growth of human malignant breast tumors by activating membrane biogenesis at the cytoplasm PMID: 23301044
- Identification of a pharmacologically tractable Fra-1/ADORA2B axis promoting breast cancer metastasis. PMID: 23483055
- Fra-1 mediates anti-fibrotic effects in the lung through the modulation of proinflammatory, profibrotic and fibrotic gene expression. PMID: 22911824
- PKCtheta signalling as an important regulator of Fra-1 accumulation in estrogen receptor positive breast cancer cells. PMID: 22286759
- study reports Fra-1 is highly expressed in the muscle-invasive form of bladder cancer and to a lesser extent in superficial bladder cancer; gene coding for AXL tyrosine kinase is directly upregulated by Fra-1 in bladder cancer and other cell lines; data demonstrate that AXL mediates the effect of Fra-1 on tumour cell motility but not on cell proliferation PMID: 21822309
- data suggest the involvement of an injury-induced Fra-1 transcription factor as a regulator of keratinocyte gene expression, which might act as an antagonistic player to restrict epithelial-driven angiogenic responses during normal skin flap integration. PMID: 21840727
- This study demonstrated ESCC patients positive for Fra-1 to be associated with poor prognosis. The findings also suggest that Fra-1 regulation may play an important role in the progression of ESCC. PMID: 22028113
- Fra-1 was induced by Epstein-Barr virus LMP2A and is essential for LMP2A-triggered MMP9 expression. PMID: 22514348
- A high frequency of Fra-1 in DCIS tumours may be associated with early events in breast carcinogenesis. Although Fra-1 expression correlated with features of a more aggressive phenotype in IDC, no relationship with overall survival was found. PMID: 21371080
- the molecular data suggest that the functional outcome of the 11q12 rearrangements is deregulated expression of FOSL1. PMID: 22411068
- Enhanced FOSL1 expression significantly correlated with high psoriasis area and severity index. High level of FOSL1 gene expression was proposed to be a marker of pathological process activity in psoriasis. PMID: 22235402
- Rhinovirus-induced MMP-9 expression is dependent on Fra-1, which is modulated by formoterol and dexamethasone. PMID: 22461694
- identified Fra-1 as a new target of miR-34a and demonstrated that miR-34a inhibits Fra-1 expression at both protein and messenger RNA levels; p53 indirectly regulates Fra-1 expression via a miR-34a-dependant manner in colon cancer cells PMID: 22198213
- Molecular characterization of the microRNA-138-Fos-like antigen 1 (FOSL1) regulatory module in squamous cell carcinoma. PMID: 21969367
- Fra-1 is an important mediator of interstitial lung disease following gefitinib treatment PMID: 21460858
- study shows that YAP could promote cell proliferation by activating transcription factor Fra-1 in oral squamous cell carcinoma. PMID: 21708480
- RT-PCR showed that FOSL1 from osteoblasts from Pfeiffer syndrome grown on PLPG acid plates were upregulated after 30 days. PMID: 21558934
- Two AP-1 components, c-Jun and Fra-1, were phosphorylated, and bound to the AP-1 binding site of the MMP-1 promoter in 143B cells. PMID: 21640141
- Activated nuclear factor kappaB and Fos-related antigen 1 are elevated in epithelial cells in lung tissues of patients with acute respiratory distress syndrome. PMID: 21526963
顯示更多
收起更多
-
亞細胞定位:Nucleus.
-
蛋白家族:BZIP family, Fos subfamily
-
數據庫鏈接:
Most popular with customers
-
-
Phospho-YAP1 (S127) Recombinant Monoclonal Antibody
Applications: ELISA, WB, IHC
Species Reactivity: Human
-
-
-
-
-
-